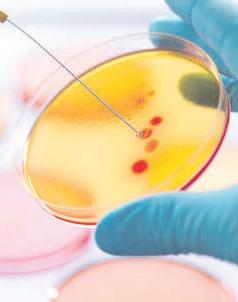

SUPLEMENTOS | EL NUEVO DÍA
MARTES, 13 DE A G O ST O DE 2024

![]()
SUPLEMENTOS | EL NUEVO DÍA
MARTES, 13 DE A G O ST O DE 2024

● Cómo hacer un plan de acción académico
● Conoce los beneficios de los certificados graduados
● Claro ofrece internet de alta velocidad para promover el éxito educativo
● Programas de vanguardia
Por Isis Morales Rosario y Dr. Jorge Berríos Lugo
El tránsito dela educaciónsecundaria ala universidad representa un cambiosignificativo para los estudiantes, marcando elinicio de unaetapa de mayor autonomía y desafiante en su formación académica. Un plan de acción académico bien estructurado es crucial para navegarcon éxitoestenuevo territorio. Para comenzar, es esencial quelos estudiantes establezcan metas claras y alcanzables, las cuales deben ser específicas, medibles, relevantes y limitadas en tiempo. Asimismo, esimportante desarrollar habilidades de gestióndel tiempo,lo queincluye la creaciónde unhorario semanal que tengaun balance entre las clases, el estudio, las actividades extracurriculares y el tiempo personal.
La organización esotro pilar fundamental; mantener un sistema para organizar notas, tareas, y fechas de entrega de trabajos y de exámenes puede marcar la diferencia. Es vital quelos estudiantessefamiliaricen conlos recursosque ofrece la universidad, como la biblioteca, loscentros detutoría y las oficinas de asesoría o consejería académica.
La participación activa en clases y gruposde estudio también fomenta una comprensión más profundade lostemas y mejora las habilidades de comunicación y colaboración.
Ademásde estosaspectos, esrecomendable queloses-

tudiantes explorenoportunidades de aprendizaje fuera del salónde clases,comointernados, investigacióny actividades de servicio comunitario voluntario, para enriquecer su experiencia universitaria y desarrollar habilidades prácticas. Estas actividadesextracurriculares fomentan el compromiso y desarrollanuna perspectiva más amplia de su campo de estudio,que ayuda a tenerun currículoatractivo para futuros empleadores. Es crucial mantener un equilibrio saludable entrela vida académicay personal,loque incluye cuidar la salud mental y física. Lapresión académica puedeserintensa, yelautocuidadono debesersu-
bestimado. Es importante que, como parte delproceso de aprendizaje, elestudiante vea necesario eldesarrollar estrategias ytécnicas derelajación, mantener una dieta equilibrada, programartiempo para actividadesrecreativas que puedan ayudar a mitigar el estrés ypromover unbienestar general. Las instituciones universitariasdeben estardispuestasy comprometidas aproporcionar servicios y actividades que fomenten oportunidadespara el desarrollo de destrezas personales, académicasy profesionales. Laintegración de equipos multidisciplinarios, entiéndase asesores académicos, consejerosprofesionales,
trabajadoressociales yfacultad, entreotros recursos,deber serservicios continuos quepuedan brindarunseguimiento constante,como parte importantedel plande acción académico.Estos servicios aportan e incrementan lasostenibilidad delamotivación a lo largo de los procesos académicos del estudiante, ademásdel compromiso con el logro de su meta. Un plan de acción académico efectivo debeser flexibley adaptarse a las necesidades cambiantes del estudiante. Los desafíos y las situaciones pueden variar con el paso del tiempoyesto sedebeconsiderar paraajustarel plansegúnsea necesario. Laautoevaluación
constante yla disposiciónpara hacer cambios pueden mejorar la eficienciay elenfoque académico. A continuación, se presenta una lista de recomendaciones prácticas para estudiantes universitarios:
1
Establecer metas académicas claras y realistas al inicio de cada semestre.
2
Desarrollar unhorario semanal que incluya tiempo para clases,estudio, descanso y actividades personales.
3 Utilizar herramientas de organización como agendas, aplicaciones o calendarios digitales.
4
Asistir a todas las clases y participar activamenteen ellas.
5 Formaro unirseagrupos de estudiopara fomentar el aprendizaje colaborativo.
6 Aprovechar los recursos académicos ofrecidospor la universidad.
7
Buscar oportunidades de aprendizaje fueradel salón de clases, talescomo internados y prácticas.
8
Mantener un estilo de vida saludable, con ejercicio regular y una dieta equilibrada.
9
Establecer una red de apoyo concompañeros, profesoresy consejerosacadémicos.
10
Evaluar yajustar elplan de acción académico regularmente paraasegurar su efectividad.
Estas recomendacionesestánbasadas enprácticascomunes y consejos de expertos en educación superior, y su implementación puede variar según las circunstancias individualesde cadaestudiante. No obstante, sirven como una guía sólidapara aquellosque inician su viaje universitario. La clavedel éxitoacadémicoresideen laproactividad,la adaptabilidad y el compromiso continuo conel crecimiento personal y profesional.
Los autores son, respectivamente, directora de Retención y decano de Asuntos Académicos de la Universidad Ana G. Méndez, Recinto de Gurabo.

BrandStudio Lead Manager: Milvia Ramírez Rivera ● BrandStudio Project Manager: Juan G. Balsa Padilla Editora: Jannette Hernández Hernández ● Subeditora: Lucía A. Lozada Laracuente
Coordinadora de Suplementos y Publicaciones Especiales: Sharian Maldonado Rodríguez










● Escogieron a la institución por su credibilidad, calidad académica y servicio
EDP University ha graduado, en el 2024, alrededor de 1,000 estudiantes en su Escuela de Enfermeríaa nivel institucional.Entre los graduados se encuentranestudiantes de enfermería residentes en Estados Unidos, que visitan la isla para realizar sus rotaciones clínicas para el grado asociadoen Enfermería.A pesarde ladistancia, escogen estudiar en EDP University por su credibilidad, calidad académica, servicio y acreditaciones. Esta modalidad semipresencial, desarrollada en el 2008, ha sido validada por sus egresados. Por otrolado, la institución cuentacon subvenciones federales para brindarles a sus estudiantes del grado asociado o bachillerato en Ciencias deEnfermería residentesenPuerto Ricoayudas económicas adicionales a la solicitud gratuita de FAFSA.Bajo elprograma Nursing WorkforceDiversity Program (NWDP), delHealth & Human Services Administration-HRSA,se ofrecen50 becas de $5,400 por año a nivel institucional. Estas se otorgan en el primer año de estudios en enfermería a estudiantesa tiempo completopara matrícula, cuotas,librosy otrosgastoseducativosrelacionados.Hayvarios requisitosparasolicitarla, entreellos: serresidentepermanente enPuerto



Rico,haber sidoadmitido algradoasociado oal bachillerato yestar matriculado endoce créditos, entreotros. Seevalúancomoprioridad alos estudiantes de nuevoingreso, provenientes de escuela superioro queno tenganexperiencia universitaria previa.
La universidad cuenta con más de 40 programas académicosen lasáreas deCiencias ySalud, Enfermería, Diseño,Administración, JusticiaCriminal, Tecnología y Justicia Criminal, que van desde gradosasociados ybachilleratos hastamaestrías. Cuenta con localidades en Hato Rey, San Sebastián, Manatí, Humacao, Villalba y Caguas, además, ofrece programas 100 % en línea.
Para información, accede a edpuniversity.edu o comunícate a través de WhatsApp al 787-593-1595 ¡Matricúlate! Saber es Poder. ¡Las clases inician en agosto!

El Colegio de Cinematografía, Artes y Televisión (CCAT) ofrece un mundo de posibilidades en el fascinante mundo de los medios de comunicación. El CCAT es elpionero enPuertoRico enofrecer cursos de grado asociado y certificado en Ingenieríade Sonido,Cinematografía y FotografíaDigital. El colegio ofrece diversas oportunidades para realizar estudios en carreras técnicas y cortas en tan solo16 meses. Puedes escogerentre FotografíaDigital,DiseñoGráfico, Cinematografía,Ingenieríade SonidoyTécnico deEdición. También ofrece ungrado asociado en Producciónde Televisión.Todosestos cursossonprácticos, dondeelestudianteaprende enestudiosprofesionales, con equipo técnico actual y en un ambiente creativo. Por 30 años, el CCAT ha educado a jóvenesyadultos enPuertoRicoen carrerascortas ygradosasociados, quienes, dentro de sus clases, desa-
rrollan destrezas laboralescon experienciasprácticasen estudiosdegrabación y laboratorios de computadoras. Los horarios disponibles son de lunes ajueves,de8:00 a.m.a3:00p.m.,en Caguasy Bayamón.El CCATtambién disponedehorarios declasesnocturnas en Bayamón, de6:00 a 9:00 p.m., de lunes a jueves.
El CCAT tiene dos localizaciones: Bayamón, Calle Dr. Veve # 51, en la Plaza de Recreo; y su centro de Extensión en la Ave. Gautier Benítez, en Caguas. ElCCA Tse encuentrarealizando matrículapara elcomienzo declases del próximo 21 de agosto de 2024. Comunícate con laOficina de Admisiones en Bayamón (787-779-2500) o en Caguas(787-653-7666). Teasistirán en completar el formulario de ayuda económica y la Beca Pell.
Visita www.DirigeTuFuturo.com para más información.
● La universidad está accesible y lista para ayudarte a alcanzar tus metas
Caribbean University te ofrece dos opcionesexcepcionales: ingresar almercado laboralde formarápida yefectiva,con sus programas enla modalidad Expreso y lascarreras cortas, diseñados para prepararte enprofesiones de alta demandaen belleza,salud yemprendimiento.
La modalidad Expreso te permite estudiarun bachillerato.Especialízate en Justicia Criminal, Gerencia, Sistemas deOficina yContabilidad. Loscursos duran ochosemanas. Seevalúa convalidaciónpor aprendizajeporexperiencia laboral.Es idealpara personas que trabajan, permitiendoun balance entre la vida estudiantil y profesional. Sus carreras cortas ofrecen conocimientosprácticos yesenciales enlos campos por especialidad que te facultan para entrar al mercado laboral. Con recintosen Bayamón,Ponce, CarolinayVega Baja,CaribbeanUniversity está accesible y lista para ayudarte a alcanzar tus metas. ¡Matricúlate hoy! Llama al 787-780-0070 o visita sus recintos.
Para información, accede a caribbean.edu, “¡Lo soñé y lo logré en Caribbean!”


















Huertas, con más de 79 años enel mercado, tiene matrícula abierta paratoda persona interesadaen estudiarbachilleratos en tres años en Ciencias en Enfermería, Administración de Empresas, Contabilidad con Auditoría, Ventas y Mercadeo 100 % online; grados asociados de dos años o menos en Terapia Física, AsistenteDental conFunciones Expandidas, Técnicode Farmacia, Tecnología en el Manejo de Informaciónde Saludy Asistente Administrativo; y gradoscertificados enTecnologíaen Electricidad,Tecnologíaen RefrigeraciónyAire Acondicionado; Estética, Entrenador Personal, Masaje Te-
rapéutico y Artes Culinarias. Pero ¿por qué es importante estudiar? Unade laspoblaciones que recibe Huertas College son jóvenes recién graduadosde escuelasuperior, que, muchas veces, no saben qué estudiar, no desean estudiaruna carreralarga oque, incluso,en ocasiones,suspadres han intervenidoen la toma dedecisiones paramotivarlosa estudiarunacarrera enparticular. Quizás,estopudiera estar relacionadocon la trayectoria de los influencers a los cuales siguen como ejemplo y queno, necesariamente, obtuvieronun gradoacadémico paralograr eléxito financiero que han obtenido o proyectan mostrar. Sin em-


bargo, este resultado no suele ocurrir en muchos casos y, por eso, es importante estudiar. El presidente de Huertas College, el doctor Isaac Esquilín, expresó en una entrevista radial para Pura Palabra,que “la universidadte dalasdestrezas blandasqueno segananen cualquier lugar.Son destrezas que van más allá del intelecto o el coeficiente intelectual. El mundo educativo bien estructurado te desarrolla cinco destrezasque teayudarán alo largo de lavida: análisis crítico e innovación,creatividad, solución de problemas complejos,trabajoen equipoyflexibilidad cognitiva” En Huertas College,no solo desarrollarásestas cincodes-



trezas, que te convertirán en un gran profesional, sino que, además de un título universitario, podrás descubrir tu propósito, forjar nuevas amistades, crecer a nivel personal, crear recuerdosinolvidables, superardesafíosy desarrollarhabilidades


de comunicación y empatía.
Explora todas lascarreras cortasde altademandalaboral que HuertasCollege tienepara ti. Las clases comienzan el martes, 3 de septiembre de 2024.
Para información, llama al
787-746-1400, extensión 3, visita su campus, accede la página web: www.huertascollege.com; o escribe al correo electrónico: admisiones@huertas.edu. En Huertas, “el futuro eres tú” ¡Te esperan!








● También festeja con orgullo su preparación de alta calidad
La EscuelaHotelera de San Juan celebra un gran logroen 2024,algraduar a 372 estudiantes en los programasde Artes Culinarias, y Panadería y Repostería Internacional, marcando un récord para la institución. Con unaempleabilidad destacadayde renombreenrestaurantes y hoteles de prestigio,
tantolocales comointernacionales, la Hotelerase dedica a brindara susalumnosherramientas para enfrentar los desafíos actuales de la industria.
“Destacamos laimportancia de unapreparación académica sólida en nuestra oferta”, afirmó Sylvia Cestero, presidenta y fundadora. Susprogramas se ofrecencon horariosvesper-
tinos únicos en Puerto Rico, transportesin costodesdeel Tren Urbano, y prácticas profesionalesen importantescentros de hostelería.
La directoraacadémica, chef NoraimaRamos, enfatizóenla renovacióndel currículocon técnicas innovadoras como barista y bartender,entre otras. Matricúlateahora ycomienza en agosto.
Visita Escuela Hotelera de San Juan en Facebook para más detalles y oportunidades disponibles.



Adelantar un semestre en verano
Grados Asociados



Bachilleratos

Maestrías
CONOCE







Grados Asociados




• Justicia Criminal*

• Administración de Empresas*
• Administración de Oficinas
• Tecnología de la Información*


• Diseño y Decoración de Interiores
• Diseño de Modas Digital
• Diseño Digital



• Biotecnología
• Técnico de Farmacia
• Enfermería
• Tecnología de Emergencias Médicas
Bachilleratos

• Ciencias de Enfermería

• Administración de Empresas con concentración en:
• Contabilidad
• Gerencia*

• Diseño y Decoración de Interiores
• Diseño de Modas Digital
• Diseño Digital con concentración en Multimedios

• Ciencias de Justicia Criminal con concentración en Ciencias Forenses


Maestrías

• Seguridad y Protección Ejecutiva
• Facturación y Codificación en Servicios de Salud
• Salud y Aptitud Física para Poblaciones Especiales

• Administración de Empresas con especialidad en Gerencia Estratégica
• Ciencias de Tecnología de la Información con concentración en:
• Programación*
• Redes*

• Ciencias Naturales
• Ciencias Políticas y Relaciones Internacionales
• Ciencias de la Salud en Terapia del Habla y Lenguaje

• Sistemas de Información
• Sistemas de Información con especialidad en Seguridad de Información e Investigación de Fraude Digital*








• Ciencias Naturopáticas
• Asuntos Públicos e Innovación Gubernamental
• Ciencias de Enfermería con especialidad en:
• Cuidado Agudo/Crítico
• Emergencia/Trauma



• “Family Nurse Practitioner”




Hay momentos en los que se necesita uncambio para echar hacia adelante. Ya eres todo unprofesional, pero sientes que debes expandir aún más tus horizontes. Losretos que presenta lavida teimpulsan aabrirte a oportunidades que te permitan lograr posiciones con buena remuneración en empresas de alto calibre. Tal vez, lo que desees sea, simplemente, llenarte de más conocimiento y ampliar tu nivelde pensamiento.Es ahídonde debes buscar unainstitución de educaciónsuperiorde prestigioytrayectoria, sobre todo, a nivel graduado, con indicadores decalidad y excelencia. Un indicador muy importante es queesta instituciónesté acreditadao cuenteconla autorizaciónparaofrecer estudios universitarios, por medio de organismos o agencias acreditadoras reconocidas. Otro indicador es que la institución universitaria ofrezca una variedad de programas y modalidades de estudios que se adapten al ajetreado diario vivir del estudiante adulto.
Todo esto ymucho más lo encuentras en laUniversidad Interamericana de PuertoRico, lo que quieredecir queesla mejoralternativa para tus estudios graduados.
La Universidad Interamericana de Puerto Rico ofrece una gran variedad demaestrías ydoctorados. Másde 80 maestrías presenciales,sobre 30 de estasa distancia,y másde 25 doctorados presenciales y tres totalmente a distancia. Hay maestrías y doctorados que se ofrecen en trimestrey otrosen semestre,entre los nueve recintos universitarios que componen la Inter.
Por ejemplo, el recinto de Ponce de laUniversidad Interamericanaofrece maestrías, certificados profesionales y doctorados en semestre, en la modalidad deeducación adistancia.

La educacióna distancia esuna experienciaplanificadaen lacualse utilizauna variedaddetecnologías sincrónicas y asincrónicas, y otras modalidadespara propiciarelaprendizaje del estudiante que se encuen-
traenun lugardistintoalprofesor. Estasexperiencias estándiseñadas paraestimular lainteraccióny laverificación del aprendizaje. Inter Ponce ofrece maestríascompletamente online enEducación enCurrículoy
Enseñanza,Diseño Instruccionaly Multimedios, Administración Internacional deEmpresas, MercadeoEstratégico, Inteligencia Empresarial Internacional, y Distribución y Logística Global, enLiderazgo deCambio Or-
ganizacional. Además, tiene tres doctorados completamente online: doctoradoen Educaciónen Liderazgoe Instrucción en la Educación a Distancia, un doctorado en Ciencias en Tecnología Aplicada en Operaciones y Logística Global,y undoctorado en Filosofía en SecondLanguage Research (se ofrece en inglés). El recintode Barranquitasofrece programas de maestríay doctorado congran demandaenPuerto Ricoy Estados Unidos. Algunos de estos programas de maestríaen semestre son Cienciasen ComputadorasenIngeniería Software, en Seguridad de Redes y ComputaciónForense, y maestrías en Ciencias en Enfermería (online) enCuidadoCrítico yenMédicoQuirúrgico. También ofrece maestrías en Ciencias enBiotecnología enBiotecnología Agrícola o Biotecnología Industrial, ambos programas enfocados enlasolución deproblemasagrícolas, ambientales y biomédicos.Inter Barranquitas también cuenta con un doctoradoen FilosofíaenBiotecnología Internacional, que es un programa único en Puerto Rico, con un enfoque en la solución de problemas agrícolas, ambientales y biomédicos.
Continúa tus estudios graduados en la Universidad Interamericana. Accede a www.inter.edu y haz admisión o matrícula. También puedes visitar presencialmente el recinto de tu preferencia o enviar un mensaje al teléfono 787-754-7597, para más información. El teléfono de Inter Ponce es el 787-284-1912 y el de Barranquitas es el 787-857-3600. El teléfono de la oficina de admisiones del Recinto Metro es el 787-765-1270. Síguelos en sus redes sociales en facebook/interocs, y en X, Instagram, Tiktok y Youtube, a través de interpuertorico.

● La institución educativa líder en estudios de la conducta humana suma un grado de bachillerato en Psicología en español a su variado catálogo de programas en modalidad de educación remota
Sí,se puedeestudiar desde cualquierparte del mundo, establecer un ritmo de aprendizaje propio, y completar un grado universitarioque abra puertas a un futuro profesional llenode oportunidades.La educación en líneaofrece esa posibilidad, y la Universidad Albizu, conocidapor sucompromiso con la excelencia académica y la diversidad cultural, ha desarrollado uno de los catálogos de aprendizaje virtual más abarcadores que existen enla regiónparael estudiode la conducta humana.
Recientemente, la Albizu incorporó el grado de bachillerato en Psicología, ofrecido completamenteen español,a


su variadoconjunto deprogramas en línea. La oferta académica en esta modalidad tiene como objetivo proporcionar unprograma educativoflexible, accesible y robusto a una enorme diversidadde estudiantes,aprovechando laextensa experiencia dela universidad enpsicología, educación y servicios de salud. El programa de licenciatura en Ciencias de Psicología ofrece a losestudiantes una base sólida en los diversos campos delasalud mentalylasdestrezasnecesarias paracontinuar estudiosen diferentes programas deposgrado. Se ofrece completamenteen línea, y está diseñado para completarse en tres años y un
semestre. Sucurrículo combinateorías cognitivas,emocionalesyde lascienciasdel comportamientocon lastendencias actuales de la psicología. Como partedel programa,serequiere quelosestudiantes completenproyectos basadosen investigación, presenten investigaciones académicasa audienciasespecíficas, y asistan o presenten sus trabajosen conferencias relacionadascon laacademia. El programabusca fomentar una comunidadde aprendizaje global que amplíe la perspectiva del estudiante, de manera que pueda valorar y respetar la dignidad detodas laspersonas, independientemente desus antecedentes, orígenes y cir-

cunstancias de vida.
Losegresados delprograma pueden encontraroportunidades laborales enuna variedad de campos tales como recursos humanos, mercadeo, servicios sociales,ventas, servicioal cliente, seguridad y orden público,hospitales yorganizaciones comunitarias.Los miembros de la facultad que ofrecen los cursos deeste programa sonprofesionales contítulos doctorales, queejercen como psicólogosprofesionales endiversos entornos, incluyendo la práctica privada, clínicas para niños, centros correccionales, y escuelas públicasy privadas, entre otros.
La ampliacióndel catálogo de aprendizaje en línea es partede laestrategiade laUniversidadAlbizu paraatender las necesidades cambiantes de los estudiantes de hoy y asegurar unaeducación rigurosa que cumplacon los criteriosde lasentidadesacreditadoras de enseñanza. “Buscamos expandir nuestro alcancemásallá delsalónde clases. Nuestrosprogramas en líneaestán diseñadospara proporcionar el mismo nivel de formaciónacadémica yapoyo que tienen todos nuestros estudiantes,con lasoportunidades que ofreceel acceso remoto, y sin perder la esencia de la universidad”, afirmó P. Edvrard Pharel, coordinador

del programa.
Los programas dela Albizu abarcan unavariedad dedisciplinas. Laoferta académica incluye, además del bachillerato en Psicología en español e inglés, los siguientes programas: bachillerato interdisciplinario con Concentración en Ciber Psicología, bachillerato en Psicología con concentración en AnálisisAplicado delComportamiento, bachilleratoen Psicología con concentración en Patología delHabla y Lenguaje, maestría en Psicología Industrial y Organizacional, maestría enCiencias deNeuropsicología, maestría en Educaciónpara EstudiantesExcepcionales, maestríaen Enseñanzade InglésparaPersonasque HablanOtrosIdiomas, maestría en Patología del Habla y Lenguaje, maestría en Consejería, maestríaen Ad-
ministración de Sistemas de Salud, doctoradoen Servicios Humanos, ycertificado graduado en Interacción Humano Animale IntervencionesAsistidas con Animales.
La Albizu provee una plataforma que sirve de punto de acceso paralos programasy servicios de educaciónen línea, y facilitala interacción entre estudiantesy profesores. Através deesa plataforma, el estudiante puede acceder a losprogramas académicos, alSistema deAdministración de Enseñanza y a enlaces pararegistrar sumatrícula ysolicitar servicios,así como a herramientas de apoyo técnico 24 horas, siete días, y a la biblioteca en líneade la universidad.
La UniversidadAlbizu continúa consu misiónde transformar vidas, através de la educación. Con el aprendizaje en línea, la Albizu cruza fronteras paratener unimpacto significativo en el panorama educativo global, yofrecer a los estudiantes las herramientas quenecesitan paraque conviertansu pasiónenuna profesión. El procesode solicitud y matrícula para los programas en línea está abierto.
Para información sobre los requisitos del programa, la matrícula y la ayuda financiera disponible en www.albizu.edu.




































¿Tienes pasión porayudar a los demás y deseas marcar la diferencia en elmundo? Atenas
University Dr. María Luisa Hernández, instituciónacreditada por la Middle States Commission on HigherEducation con másde 26añosdesarrollando profesionales dela salud,te proporciona una experiencia educativa emocionante y transformadora.
Imagina estudiar enun entorno interprofesional, donde la innovación es parte fundamen-
tal de laexperiencia educativa. Aprende enel primerhospital simuladode PuertoRico yel Caribe, un espacio altamente tecnológico querecrea escenarios clínicos complejos en un ambiente seguro y controlado. Combina cursosteóricos en modalidad a distancia con prácticas y laboratorios presenciales,diseñados parabrindarte una formaciónintegral yde vanguardia.
En Atenas University no solo te ofrecen una educación, sino que también te brindan una red
de profesionales que te acompañan en tu trayectoria educativa. Además, cuenta con ayudas económicasdisponibles, una ubicación estratégica enla zonanorte centralde Puerto Rico y un amplio estacionamiento gratuito.Su personalestá presentepara asegurarse de quetengas todo lo que necesitas para tener éxito.
Únete aAtenas Universityy sé parte deuna institución que se dedica a formar profesionales comprometidos con la salud y el

bienestar de la sociedad. Ya ofrece cuatro nuevos programas de maestría: dos en Ciencias de Enfermería y dos en Ciencias de la Salud. ¡Tu futuro brillante en el campo de la salud comienza en ‘TuNueva Universidad’! ¡Matricúlate hoy en AtenasUniversity Dr.María Luisa Hernández y comienza tu camino haciauna carreraprofesional apasionante y significativa!Su ofertaacadémica incluye maestrías, bachilleratos, grados asociados y programas técnicos. ¡Allí te esperan!



● Columbia Central University cuenta con diferentes certificados, grados asociados, bachilleratos y hasta maestrías
La decisión de escoger una carrera profesional quevaya acordecon tusgustos ymetasde vida no es una decisión que se debe tomar a la ligera. Este es un paso crucial que marcará tu futuroprofesional ypersonal, yque ColumbiaCentralUniversity (CCU) entiendelo importantequees paratiylos tuyos. Por eso, te ofrece las herramientas necesarias para construir un futuro profesional en la carrera que deseas.
EnCCUmotivan asusestudiantes a seguirsu pasión y convertirla en una carrera pro-
fesional exitosa. Por eso, cuenta con diferentes certificados, grados asociados, bachilleratos y hasta maestríasen Salud, Administración, Tecnologíay Artes Aplicadas.Además, sus modalidades se adaptana tus necesidades, con ofrecimientos declases presenciales,híbridas o en línea. CCU facilita el acceso a educación de calidad a estudiantes de toda la isla. Por tal razón, cuentacon recintos enCaguas, Carolina,Bayamón y Yauco.
Como instituciónacreditada por la Middle States Commission on Higher Education (MS-



CHE), se rige por los más altos estándares de educación y mantiene sus programasa la vanguardia con las necesidades de cadacarrera en su campolaboral. Delamisma manera,busca alianzascon entidades públicas y privadas que invierten en tu futuro profesional y garantizan que pondrás en prácticalo aprendido en clase.
Conoce sobre cómo puedes comenzar tu carrera profesional en lo que te apasiona, llamando al 787-743-4315 o accede a columbiacentral.edu.


























SEPTIEMBRE 2024


Beneficios:
Laboratorios equipados
Facultad experta
Fácil admisión
Carreras cortas
Requisitos de Admisión:
Solicitud de admisión
Diploma de 4to año o transcripción de créditos Hoja de vacunas (menores de 21 años)
Orientaciones telefónicas
787-746-1400 Ext. 3
Orientaciones por WhatsApp
787-920-6606








Bachilleratos (3 años)
Ciencias en Enfermería
Bachillerato en Ventas y Mercadeo (100% online)
Administración de Empresas, Contabilidad con Auditoría
Grados Asociados (2 años o menos)
Enfermería
Técnico de Farmacia
Tecnología en el Manejo de Información de la Salud
Terapia Física
Asistente en Terapia Ocupacional
Asistente Dental con Funciones Expandidas
Asistente Administrativo
Grados Técnicos (1 año o menos)
Tecnología en Electricidad
Tecnología en Refrigeración y A/C
Artes Culinarias
Masaje Terapéutico
Estética
Entrenador Personal
● Caribbean Aviation Training Institute, Inc., te prepara para hacer realidad tu pasión por el mantenimiento y la reparación de los aviones
Con más de 18 años educando, Caribbean Aviation Training Institute, Inc., es una institución especializadaen mecánicay electrónica de aviaciónque te ofrece la oportunidad de transformar tu pasión por los aviones en una carreragratificante y de altademanda. Aprenderásde instructores expertos, combinando lateoría y lapráctica en un programa corto. Adquirirás conocimientostécnicosavanzados ydesarrollarás habilidades esenciales para la resolución de problemas y el trabajo en equipo, preparándotepara sobresalir en la industria aeronáutica.
Cada día, te acercarás más a convertirte en unprofesional altamente cualificado,listo paraenfrentar los desafíosdel mantenimiento y la reparación de aeronaves.
Únete a Caribbean Aviation Training Institute y despega hacia un futuro lleno de posibilidades, donde el cielo noes el límite, sinosolo el comienzo. La mecánica de aviación es másque unaprofesión, esuna vocación apasionanteque tellevaráa nuevasalturas.¡Matricúlate hoy ycomienza tu viajehacia una carrera llena de oportunidades!
Para información, llama al 787-690-7865.


La Escuela de Artes
Plásticas y Diseño (EAPD) es la única institución de educación superior enPuerto Ricoque ofrece un bachillerato en Artes Plásticascon ochoconcentraciones: ArtesGráficas, Diseño de Modas, Diseño Gráfico, DiseñoIndustrial, Educación del Arte, Escultura, Imageny Movimiento,yPintura.
También es la única universidad enla islacuyos programas académicos están acreditados por la National Association of Schools of Art and Design (NASAD).
La EAPD cuenta con un programa de cursos cortos que incluyen:Enmarcado 1,Enmarcado 2,Pintura Abstracta, CosturaBásica, CosturaIntermedia, Artepara Niños, Acuarela, Uso ymanejo de laptops (+65), Fotografía Digital, PinturaBásica, Pintura Intermedia yCerámica en Torno,entre otros.Paraver todos loscursos disponibles, puedes visitar su página web
● Este es tu momento de descubrir nuevas habilidades en el mundo de la cultura, en la Escuela de Artes Plásticas y Diseño
en www.extension.eap.edu. Estees tumomento dedescubrirnuevas habilidadesenel mundo de la cultura, a través de cursos cortos en arte y diseño.



● Contar con las herramientas adecuadas es esencial para facilitar este proceso, ya sea que estés iniciando o continuando tu carrera universitaria
El comienzo de clases es siempre unmomento emocionante, llenode oportunidades para el crecimiento personaly profesional. Contar con las herramientas adecuadases esencial para facilitar este proceso,ya seaque estésiniciando o continuandotu ca-
rrera universitaria. Actualmente, elinternet es una delas herramientasmás valiosas y necesariaspara los estudiantes. Como parte de su compromiso con la educación y reducir la brecha digital, Claro ha desplegadola redde fibra ópticamás grandedePuerto Rico, que le permitea los es-
tudiantesnavegar elinternet de alta velocidad con una conexión dedicada y estable para el hogar, capaz de alcanzar una velocidad de hasta1,000 megas de download y 1,000 megasde upload, abriéndoles un mundode posibilidadespara acceder información y mejorar el aprendizaje.
DISFRUTA DE UNA
NAVEGACIÓN ESTABLE Y ROBUSTA
No hay nada más frustrante que esperara queuna página cargue cuando tienes múltiples tareas pendientes. La fibra óptica soluciona este problema, permitiéndote cargar páginas de forma simultánea y efi-

ciente, inclusocuando tienes varias pestañas abiertas con vídeos y fotos. De esta forma, puedestrabajar enmúltiples tareasa lavez sininterrupciones, loque esesencial para mantener tu productividad.
CONEXIÓN EXCLUSIVA
PARA CLASES VIRTUALES
En un mundo cada vez más digital,las clasesremotasy virtuales se han convertido en unaparte esencialde lavida universitaria. Si granparte de tus tareas académicas las realizas encasa, contarcon un hogar conectado es fundamentalparacumplir tusmetas.El internet de fibra óptica garantizauna experienciadeaprendizaje fluida y sin interrupciones, permitiéndote asistir a clasesenlínea, participarenvideoconferencias en tiempo real, y descargarmateriales de estudio sin problemas.
TRASMISIÓN DE DATOS
SIN LATENCIA
El internet de alta velo-
cidadno solofacilita labúsqueda de información, sino quetambién esunaherramienta poderosa para el aprendizaje colaborativo y la creaciónde contenidos.Ya seaque necesiteselaborar audiovisuales outilizar aplicacionescon tecnologíade inteligenciaartificial (IA),con la fibra óptica de Claro podrás recibir mayor velocidad y capacidada lahora desubir contenidos de audio o vídeo a portales digitales;realizar transmisión en vivoen alta definición;compartir odescargararchivos pesados,y trabajar en la nube.
CONEXIÓN CONTINUA Y SIN INTERRUPCIONES
Paralos estudiantesuniversitarios, el aspecto social es tanimportante comoel académico.El internetposibilita nuevas formas de relacionarsey divertirseenredessociales, aplicacionesdigitales, yjuegos enlínea, brindando múltiples oportu-
nidadespara conocergente, compartir y disfrutar. Asimismo, lafibra ópticade Claro garantizala continuidaddel servicio durante la interrupción del servicio eléctrico comercial. Esto quiere decir que, siempre quetengas una fuente de energía en tu propiedad (comercial, batería o generador propio), el servicio de internet permanecerá activo y continuo. Este año,atrévete aexperimentar unanueva forma de aprender y divertirte con el internetde altavelocidadque te ofrece Claro. Prueba tu velocidad y descubre cómo puede transformartu experiencia universitaria.
Para información y conocer la disponibilidad de fibra en tu área residencial, llama al 1-833-642-5276 o al 787-775-0000, accede a https://tienda.claropr.com/, o visita los Centros de Atención al Cliente, tiendas y agentes autorizados.




● No solo podrás montar tu propio negocio, sino que también recibirás trucos para arreglar y mejorar tu casa
¿Sabíasque enPuerto Rico nosfalta manode obra cualificada en las distintas ramas de la construcción? Por eso,el Instituto de Carpintería Puerto Rico te ofrececursos cortosde tres meses para que te conviertas en un “duro” en lacarpintería, la ebanistería, el gypsum board y la fabricación de puertas y ventanasdealuminio. Y,sí,estos cursos son para todos.
En el Instituto de Carpintería Puerto Ricoestán superemocionadosdever cadaveza más mujeres en este campo.
¿Qué es lo mejor de estudiar aquí? Queno soloaprendes a montar tu propio negocio, sino quetambién tebrindanlos


trucospara arreglarymejorar tu casa, y tenerla de show para esaocasión especial.Asíque, si algose rompe,tú mismolo puedes arreglar.
En el Instituto de Carpintería Puerto Rico usan herramientas sencillas para quetodo lo que aprendas, lo puedasponer en práctica fácilmente.
Anímate,aprende delos mejores, y ayuda a Puerto Rico a levantarse, mientras te labras un futuro brillante.
Comunícate a través del 787-666-9287 (llamadas, mensajes de texto o WhatsApp) o envía un correo electrónico a: institutode carpinteriapr@gmail.com/.





● Como parte de la oferta académica universitaria, los certificados graduados generan ventaja competitiva



Por Renia Rosa
La educación postsecundaria, tantoa nivel subgraduado como graduado, contribuye no solo al crecimiento personal y profesional de cada individuo alque impactadirectamente, sinoque tambiénse sitúacomo unosde losejes dela estructura social. De esta manera, la educación de calidad es uno delos principalesobjetivospara lograreldesarrollo sostenible.
Además de los grados académicos que, a nivel graduado, pudieran ser más conocidos, como las maestrías y los doctorados, la oferta educativa de las institucionespuede incluir certificados. El Reglamento para ellicenciamiento deinstituciones de educación postsecundaria enPuerto Rico define elcertificado denivel universitario graduado como un “reconocimiento oficial cuyaestructura curricularestá constituida por cursos de nivel de maestría o doctorado”. Estos pudieranser conducentes a un grado, pero dependerá de las característicasde cada programa.

“Hahabido unamayorcantidad de estudiantes que les ha interesado [cursar certificados graduados]”, afirmó el vicepresidente de Asuntos Académicos de la Universidad Ana G. Méndez (UAGM), doctor EdgardoRosaly Manfredi,sobre el auge pospandemia.
En elcaso dela institución mencionada, los programas másbuscados sonlosreferentes a negocios, de acuerdo con el entrevistado. Mercadeo, Gerencia de Calidad, Gerencia de Proyectos y Seguridad de Sistemas de Información son algunas de las áreas de estudio de la División Académica deNegocios, TurismoyEmprendimiento de la UAGM.
Otros, como el certificado graduadoen Autismo,enDesarrollo Comunitarioy en Asuntos Públicosen Servicios Humanos, forman parte del ofrecimiento educativode la universidad.En cuantoalcertificado graduado en IntervenciónAsistida porAnimales, Rosaly Manfredi indicó que estenuevo programacomplementa elprograma doctoral que la universidad ofrece en Medicina Veterinaria.
Encomparación conuna maestría, el certificado graduado se obtiene con menos créditosuniversitarios. “En este momento, tenemos alrededor de 22 certificados graduados quefluctúan entrelos18 ylos 24 créditos”,mencionó. No obstante, hayprogramas, comoel certificadoposbachillerato en Tecnología Médica, que, porsunaturaleza ylasregulaciones dela profesión,requieren más créditos.
Así como la duración del programa es menor, un certificado graduadose centraenhabilidades y temas específicos, y no requiere hacer una tesis. “Los certificados van directamente a cursos sumamente especializados”, comentó el vicepresidente de Asuntos Académicos de la UAGM. A modo de ejemplo, si una persona está interesada en una nueva vacanteen la empresa en laque actualmente labora, pero no cuenta con todas las competencias necesarias para ejercer el rol, podría optarpor elcertificadograduado para mejorarsus cualificaciones. Las personas que quieren capacitarse en un área diferente a la de su bachillerato también puedenconsiderar completarun certificadograduado.
“Es una decisión bien individual”, apuntó Rosaly Manfredi, acerca de la elección entre uncertificado graduadoy unamaestría. Laspersonas quecuentantanto conunbachillerato o una maestría como con un doctorado pueden beneficiarse de las ventajas competitivas que ofrecen los certificados graduados.
“Hemos notado que los empleadores lo ven muy positivo”, aseveró enrelación con laperspectiva delospatronos hacia loscertificados graduados. “Muchas [de las personas que obtienenun certificado graduado] se motivana completarlamaestría. Esunporcentaje alto”, dijo.
La autora es periodista colaboradora de Suplementos.
